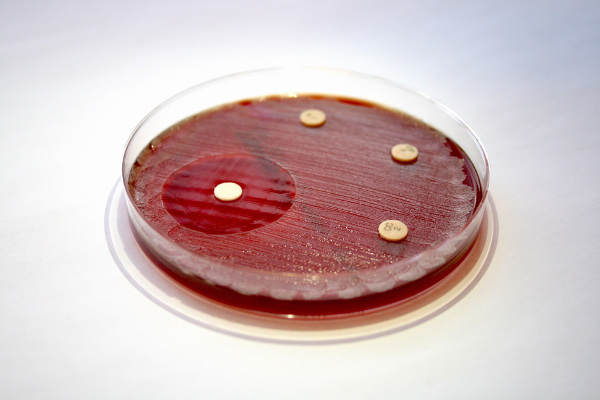

Bahnbrechende Technologie prämiert

Viele Menschen, die unter chronischen Hauterkrankungen mit einer entzündlichen Komponente (wie Neurodermitis) leiden, profitieren bereits von einem neuartigen Therapieansatz. Ein enzymatischer Wirkstoff – das Endolysin Staphefekt – beseitigt gezielt den häufigsten Entzündungserreger, das Bakterium Staphylococcus aureus (S. aureus). Dieser auf Endolysintechnologie basierende Ansatz der Firma Micreos ermöglicht nicht nur eine innovative Behandlung entzündlicher Hautkrankheiten, sondern ist auch eine bahnbrechende Alternative zu Antibiotika. Als solche wurde die Technologie beim niederländischen Vorentscheid von „Ideas from Europe“ zum Sieger gekürt (Link zum Vortrag, Dauer: 5 Minuten).
Die europäische Initiative „Ideas from Europe“ will Ideen für die größten Herausforderungen der Gesellschaft entwickeln und bahnbrechende Technologien unter Einbeziehung von Öffentlichkeit, Investoren und Entscheidern vorantreiben. Die Jurybegründung für den niederländischen Sieger lautete: „Wir haben Micreos ausgewählt, weil die Technologie dieses Unternehmens bereits zehntausenden Menschen hilft und wir überzeugt sind, dass Micreos‘ Alternative zu Antibiotika lebensverändernd für Millionen sein kann.“ Mark Offerhaus, CEO des Biotechnologieunternehmens, hat inzwischen die Niederlande im Halbfinale in Tallinn (Estland) vertreten und dort die Technologie, auf die sein Unternehmen mit Staphefekt und der Marke Gladskin bei der Behandlung von Hautentzündungen setzt, präsentiert. Micreos zählt nun zu den zehn Finalisten, die im Frühjahr 2018 in Den Haag antreten werden.
Das Endolysin Staphefekt, das ausschließlich Bakterien des Typs S. aureus erkennt und gezielt nur deren Zellhülle zerschneidet, ist eine neue und nachhaltige Alternative zu Antibiotika. Diese wertvollen Medikamente sind durch Resistenzen, die wegen massiven oder bedenkenlosen Einsatzes vermehrt auftreten und sich ausbreiten, in ihrer Wirksamkeit bedroht. Davor warnt seit Jahren die WHO, da auch keine wirklich neuen Antibiotika in den nächsten Jahren auf den Markt kommen werden. Endolysine sind hier eine der Alternativen zu Antibiotika: sie töten auch antibiotikaresistente Bakterien ‚ihrer‘ Wirtsart ab, ohne selbst auf Seiten der Bakterien Resistenzen hervorzurufen.
Für Neurodermitiker ist Staphefekt bzw. Gladskin als Therapiemöglichkeit besonders interessant, denn 70 bis 90 Prozent der Betroffenen tragen das Bakterium S. aureus auf der Haut, wo es während der Schübe massenhaft in den Ekzemen vorkommt und die Entzündungen verstärkt oder verursacht. Antibiotika sind nur selten das Mittel der Wahl, weil die Erkrankungsdauer und die wiederholten Schübe gegen den Einsatz von Antibiotika sprechen. Weitere antibiotikaresistente Stämme könnten entstehen und vorhandene resistente Keime in ihrer Ausbreitung gefördert werden. Gegen Antibiotika spricht außerdem, dass das Mikrobiom der Haut - die ‚Hautflora‘ - bei Neurodermitis bereits viel weniger vielfältig als auf gesunder Haut ist. Die meisten Mikroorganismen auf unserer Haut sind jedoch für eine gesunde Haut wichtig. Doch Antibiotika unterscheiden nicht zwischen für uns schädlichen oder nützlichen Bakterien, sodass diese die schützende Hautflora weiter schädigen.
Staphefekt bietet damit einige Vorteile im Vergleich zu Antibiotika: Es wirkt gezielt auf die Bakterienart S. aureus, ohne Nebenwirkungen auf die Hautflora. (2) Das Enzym fördert selbst keine Resistenzbildung, wirkt aber ebenso effektiv gegen antibiotikaresistente S. aureus-Varianten, z. B. gegen den ‚Krankenhauskeim‘ MRSA. (3)
Diese Eigenschaften ermöglichen sowohl eine langfristige Unterdrückungs- als auch eine Erhaltungstherapie bei S. aureus-bedingten Entzündungen der Haut, die sich durch Symptome wie Juckreiz, Rötung, Schwellung, trockene Haut, etc. zeigen können. Sogar eine vorbeugende Behandlung bei gefährdeten Patienten ist möglich.
In Einzelfallstudien und Produkttests mit niederländischen, belgischen und deutschen Patientenorganisationen (wie dem DNB) hat Gladskin sehr gute Wirkung gezeigt. Weiterhin fiel auf, dass bei etwa der Hälfte der Tester der Kortisonbedarf zurückging. Diese Fragestellung ist eine von vielen, die z. Zt. in einer klinischen Doppelblind-Studie zu Gladskin mit 100 Neurodermitispatienten an der Erasmus Uniklinik in Rotterdam abgeschlossen wird. Die Veröffentlichung der Ergebnisse wird im ersten Halbjahr 2018 erwartet. (4370)
Staphefekt auf MRSA-bewachsenem Nährboden:
Die drei Antibiotika-getränkten Plättchen (rechts vorn und hinten, hinten Mitte) haben keinen Einfluss auf das Wachstum von MRSA. Nur Staphefekt (Plättchen links) tötet MRSA ab und verhindert jegliches Wachstum der Bakterien.













